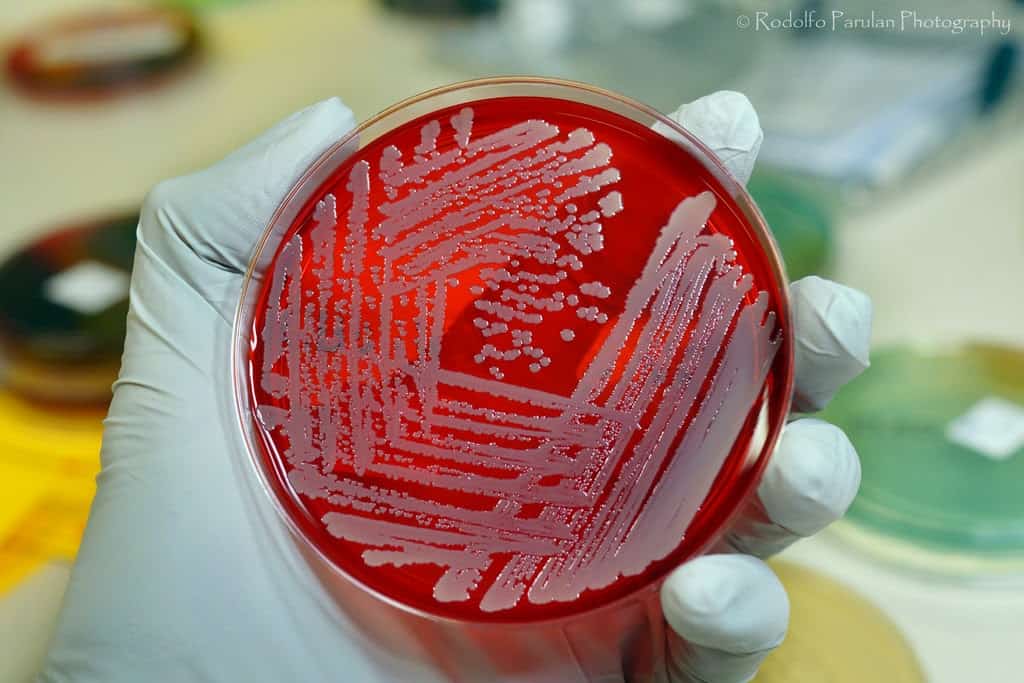

Các nhà nghiên cứu đến từ Viện Doherty, Trường ĐH Melbourne (Úc) vừa cảnh báo một loại siêu vi khuẩn “họ hàng” của MRSA (tụ cầu vàng kháng Methicillin) đang lan rộng ra các bệnh viện trên toàn thế giới.
Loại siêu vi khuẩn nói trên – có tên khoa học Staphylococcus epidermidis (S. epidermidis) – có thể gây nhiễm trùng nặng, thậm chí dẫn đến tử vong. Đây là nguyên nhân hàng đầu gây nhiễm trùng ở bệnh viện nhưng ít được biết đến so với MRSA.
Các nhà nghiên cứu đến từ Viện Doherty đã xem xét hàng trăm chủng S. epidermidis từ 78 bệnh viện ở 10 quốc gia. Họ tìm thấy ba chủng S. epidermidis phụ đã lan rộng trên toàn cầu và có khả năng kháng lại gần như tất cả loại thuốc kháng sinh hiện có trên thị trường.
Ông Ben Howden, tác giả công trình nghiên cứu được công bố trên tạp chí Nature Microbiology nói trên, cho biết S. epidermidis tồn tại trên da người và lây nhiễm cho những người bị suy giảm hệ miễn dịch, cao tuổi hoặc cấy ghép các bộ phận giả.

Siêu vi khuẩn Staphylococcus epidermidis. Ảnh: Microbiology Info
Theo ông Jean Lee của Viện Doherty, S. epidermidis tạo ra sự thay đổi nhỏ trong ADN của chính nó, dẫn đến sự đề kháng với hai loại kháng sinh phổ biến nhất thường được sử dụng để điều trị nhiễm trùng tại bệnh viện.
Điều này khiến các nhiễm trùng liên quan đến S. epidermidis khó điều trị và tốn kém hơn. Tuy nhiên, những người tử vong do S. epidermidis thường là các bệnh nhân mắc bệnh nặng trong bệnh viện.
Các nhà nghiên cứu cho biết họ tin rằng siêu vi khuẩn S. epidermidis đang lây lan nhanh chóng do việc sử dụng kháng sinh liều cao trong các đơn vị chăm sóc đặc biệt, nơi bệnh nhân được cho sử dụng những loại thuốc kháng sinh mạnh nhất.
Tổ chức Y tế Thế giới (WHO) từ lâu đã cảnh báo về mối nguy hiểm của việc lạm dụng thuốc kháng sinh, qua đó tạo ra các loại vi khuẩn kháng kháng sinh mới.
Một nghiên cứu khác của Úc được công bố hồi tháng trước cho thấy một số loại siêu vi khuẩn tại bệnh viện đang ngày càng “thích ứng” với những chất khử trùng có cồn trong các loại nước rửa tay và chất khử trùng được sử dụng ở bệnh viện.
Theo NLĐ